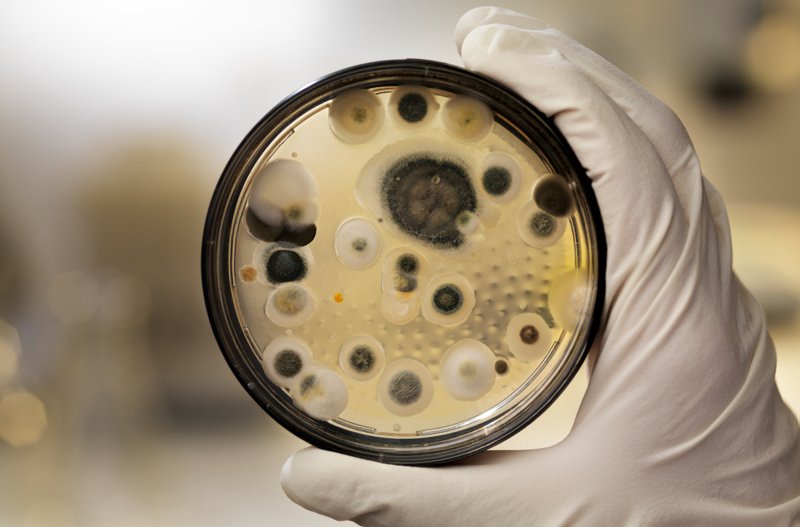
Plesne môžu mať mnoho podôb

Spóry alebo výtrusy sú drobné rozmnožovacie čiastočky, ktoré sa šíria vzduchom podobne ako peľ alebo prach. Veľkosť plesňových spór sa zvyčajne pohybuje medzi 3 a 12 mikrometrami, sú teda voľným okom neviditeľné. Vďaka tejto malej veľkosti sú schopné prenikať hlboko do dýchacích ciest.
Keď sa spóry uchytia na nejakom vyhovujúcom povrchu a majú vhodné podmienky (vlhko, teplo, živiny), vyrastie z nich plesňové ložisko, ktoré vyraší na povrch v podobe známeho plesňového povlaku. Ten môže mať rôznu farbu – najčastejšie zelenú, sivú, hnedú až červenú, čiernu aj bielu. Aj jeden druh plesne môže v rôznych podmienkach vyzerať rôzne.
Z ložísk plesní sa do vzduchu uvoľňujú nové spóry, ktoré si opäť budú hľadať miesto na uhniezdenie.
Pokoj nie je ani vonku, ani doma
Plesňové alergény sa vyskytujú tak vo vonkajšom, ako aj v domácom prostredí. Niektoré druhy plesní tam aj tam.
V budovách rastú plesne všade, kde na to nájdu vhodné podmienky, predovšetkým dostatočnú vlhkosť a teplotu. Vo vnútornom prostredí niektorých budov predstihnú výskyt roztočov. Najväčšie koncentrácie spór domácich plesní zaznamenávame v zimných mesiacoch. Najčastejšie ide o druhy Aspergillus, Penicillium, Alternaria, Rhizopus a Mucor.

Vo vonkajšom prostredí bývajú spóry plesní podstatne hojnejšie než peľ. Podobne ako pri peli rozhodujú o množstve spór plesní v ovzduší klimatické podmienky. Vrcholy výskytu plesní v ovzduší zaznamenávame na vrchole leta a v skorej jeseni, najmä za teplého a vlhkého počasia. Spóry sa tiež uvoľňujú pri prvých jesenných mrazoch. Typické vonkajšie druhy plesní sú Alternaria, Cladosporium, Helminthosporium, ďalej askospóry a bazídiospóry.
Okrem spór plesní sa vo vzduchu môžu vyskytovať aj výtrusy niektorých húb (hríby, drevokazné huby) alebo jednobunkové huby zvané kvasinky. Ľudia alergickí na plesne môžu na obe tieto skupiny spór rovnako skrížene reagovať.
Náš tip: Pri alergii je nevyhnutné chrániť dýchacie cesty pred vdychovaním plesňových spór. Podrobnosti nájdete v našom článku Ako sa zbaviť alergie na plesne obmedzením kontaktu s nimi v byte aj vonku.
Niektoré plesne sa človek naučil využívať vo svoj prospech, napríklad na výrobu liečiv (antibiotík, enzýmov) alebo úpravu potravín (syrov, sójových výrobkov).


